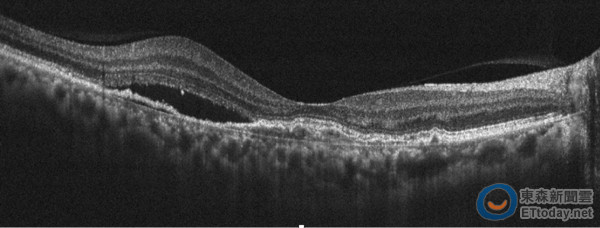

▲「橘紅色息肉血管瘤」長視網膜,黃斑水腫婦右眼總是糊。(圖/示意圖/達志影像)
記者嚴云岑/台北報導
一名60歲女性,近一周總覺得視力模糊,看電視單手遮眼,還發現右眼看不到。就醫後發現視力僅存0.3,視網膜有橘紅色息肉狀血管瘤,合併有黃斑部水腫,經非侵入性光學共軛斷層血管掃描儀診斷為「老年性黃斑性病變亞型——多足型脈絡膜血管病變」,以光動力療法合併多次眼內藥物抗血管內皮生長因子注射後,視力進步到0.6,黃斑部積水完全恢復。
台北榮總眼科部黃怡銘醫師表示,若單眼視力模糊與中央視野變暗,有可能是老年性黃斑部病變,一旦發現視力降低應儘速就醫治療。目前治療方法包含眼內藥物注射,能有效減少黃斑部積水達到視力進步,或是光動力療法助於息肉血管瘤的消失或減退,也可以採取合併療法,雙管齊下,但是所有的治療方式需要與眼科醫師共同討論。

▲眼底可見橘紅色息肉狀血管瘤。(圖/台北榮總提供)
過去診斷方式需注射螢光劑或循血綠進行血管攝影,經由影像上的螢光劑或循血綠滲漏點,判讀出不正常的新生血管,費時1-2小時,部份患者會出現噁心、嘔吐、頭昏不舒服等過敏症狀,且侵入性檢查風險較大。而傳統治療方法是採取眼球內藥物注射「抗血管內皮生長因子」(Anti-VEGF),但常常造成黃斑部反覆水腫,需要多次反覆的注射,造成病患及醫師的沈重負擔。
為快速確診,臺北榮總眼科部於2014年引進「非侵入性光學共軛斷層血管掃描儀(OCT angiography)」,不需散瞳、打顯影劑,只要光學掃描,可即時獲得視網膜斷層及血管影像,對人體傷害少,將視網膜疾病檢查帶入非侵入性檢查的年代。在50例老年性黃斑部病變病患中,針對其中31例多足型脈絡膜血管病變的病患,利用非侵入性光學共軛斷層血管掃描儀,診斷率高達九成,惟眼睛無法固定注視或視網膜大量出血者則不適用。
▲眼底斷層掃描可見黃斑部積水。(圖/台北榮總提供)
為提升治療效果,光動力療法(PDT)將特殊光敏感藥物(Visudyne)注入血管內,待其到達新生血管病灶處,再以特殊波長紅光雷射照射病灶,讓藥劑活化,活化後的藥物可使脈絡膜的新生血管達到栓塞及萎縮目的,不會對正常視網膜造成傷害,僅有視網膜下出血或是玻璃體出血少數併發症,為治療多足型脈絡膜血管病變新選擇,目前已獲健保署核准通過,為黃斑部病變患者一大福音。





讀者迴響